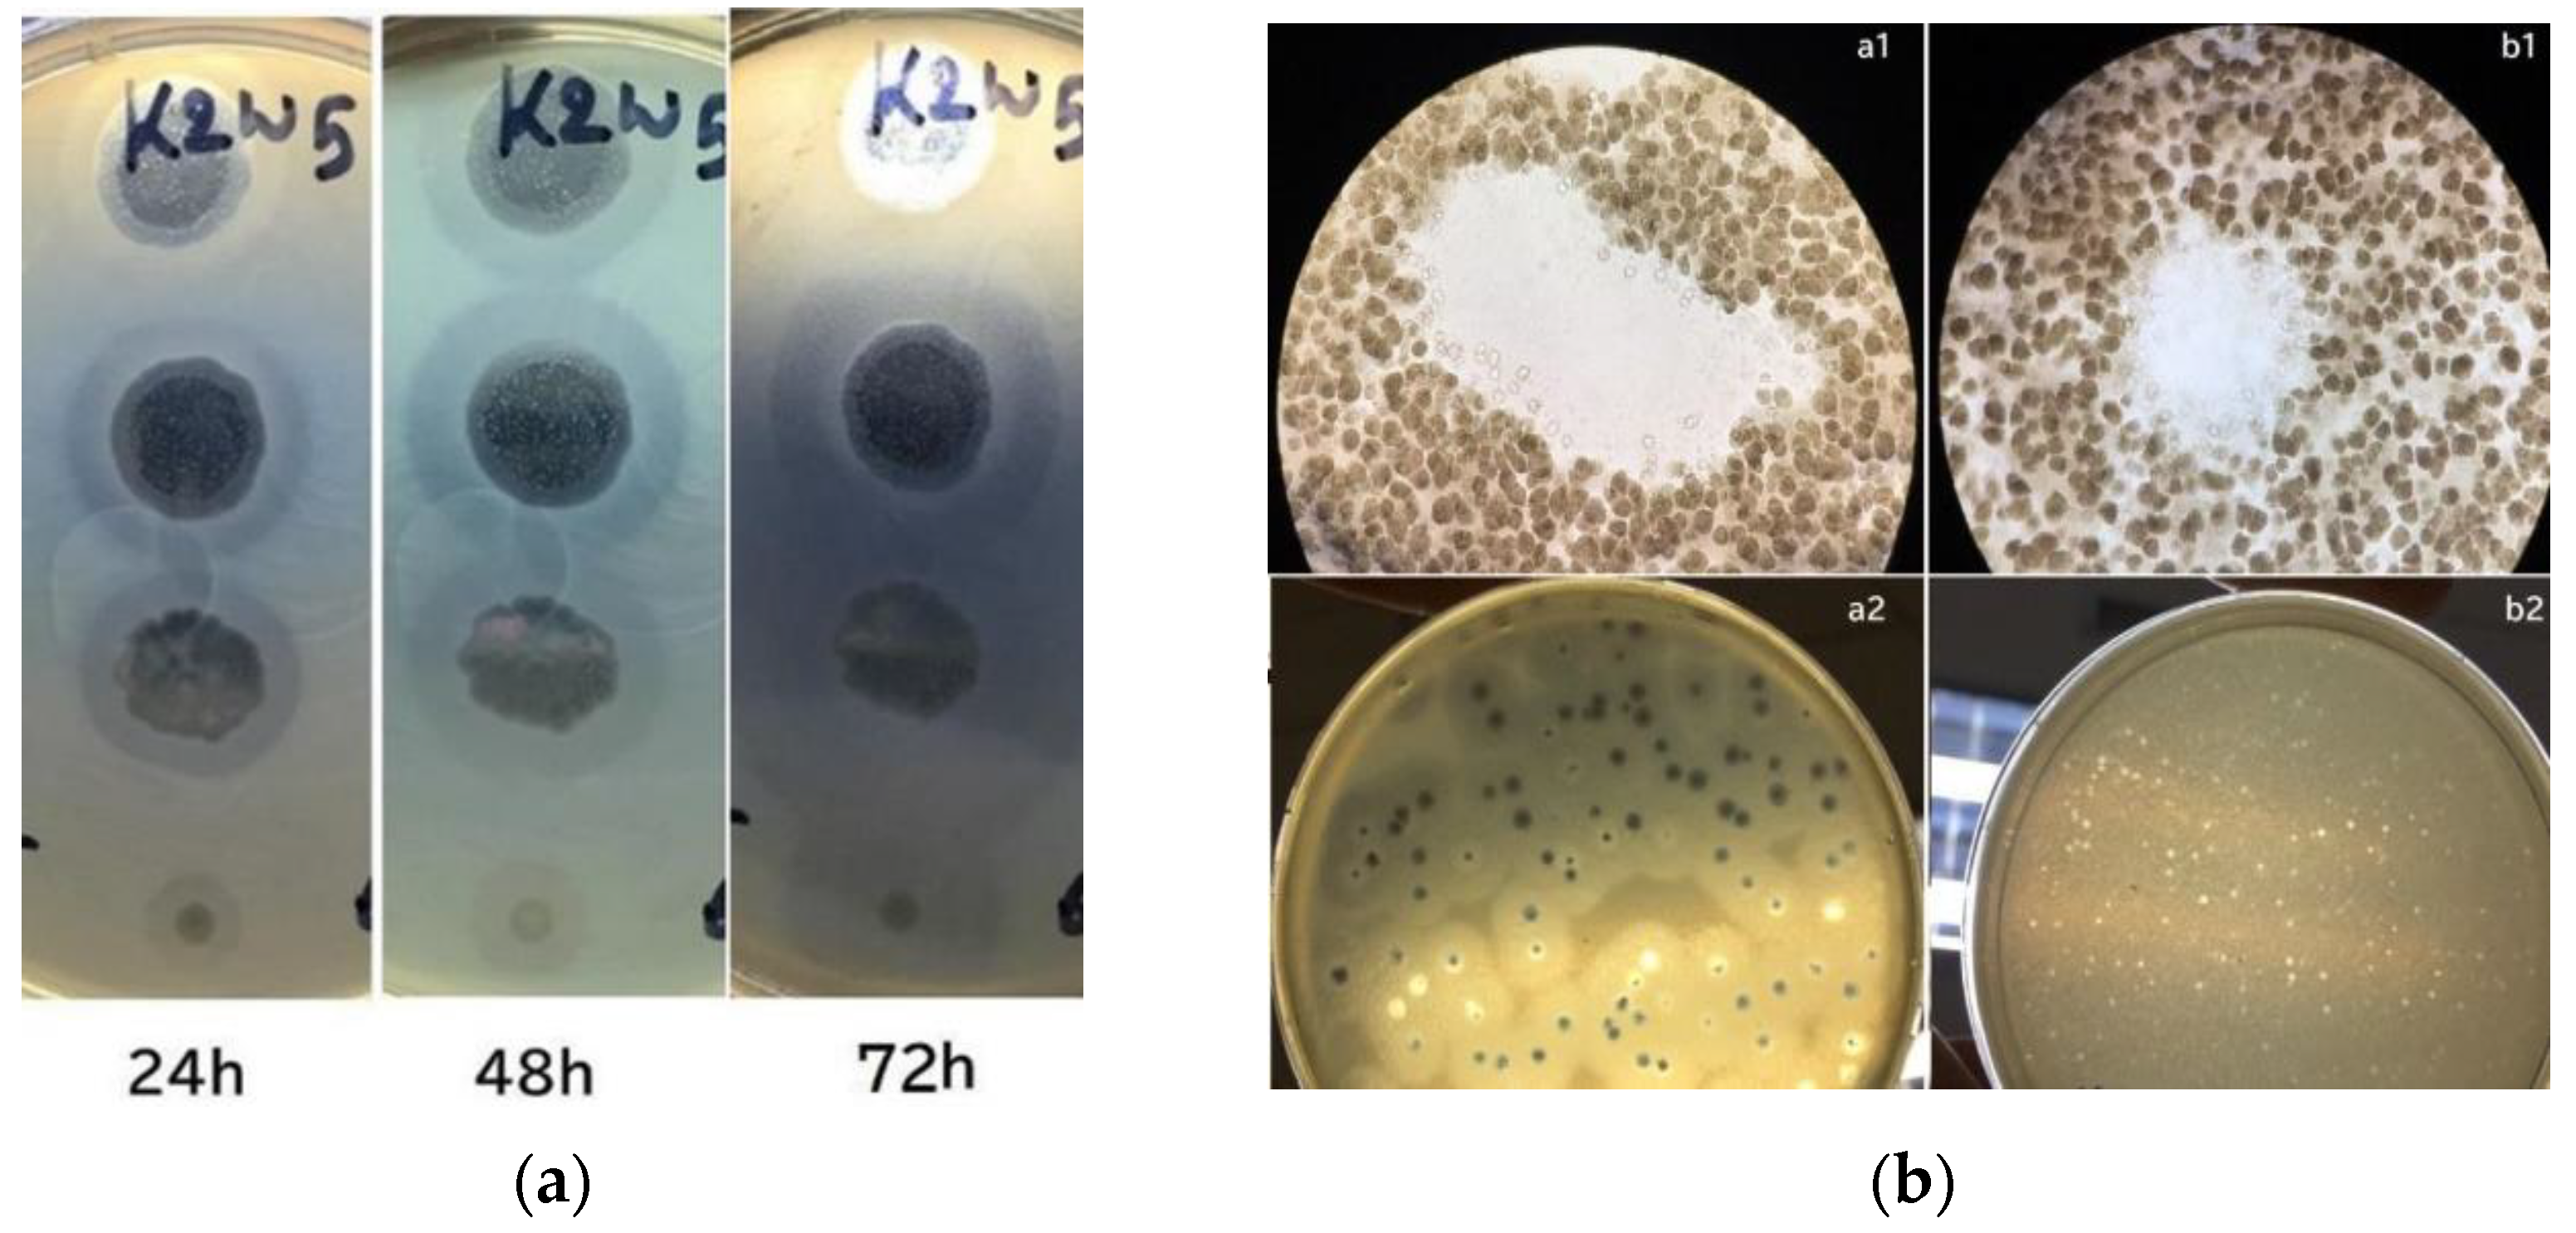

In Vitro Activity, Stability and Molecular Characterization of Eight Potent Bacteriophages Infecting Carbapenem-Resistant Klebsiella pneumoniae
Abstract
1. Introduction
2. Materials and Methods
2.1. Bacterial Strains and Culture Conditions
2.2. One-Step Growth Curve
2.3. Sensitivity of Bacteriophage to Long-Term Storage, Temperature, Chloroform and pH
2.4. Optimal Multiplicity of Infection (MOI)
2.5. Bacteriophage Adsorption to Host Bacterial Cells
2.6. Bacteriophage Structural Protein Analysis by SDS-PAGE
2.7. DNA Extraction, Restriction Analysis and RAPD
2.8. Bacteriophage Genome Sequencing
3. Results
3.1. Phage with Active Depolymerase Activity
3.2. Low MOI Is Optimal for Bacteriophage Propagation
3.3. One-Step Growth Curve
3.4. Adsorption Parameters
3.5. Effect of Temperature on Bacteriophages
3.6. Effect of Different pH Values on Bacteriophages
3.7. Effect of Chloroform on Bacteriophages
3.8. Long-Term Storage of Bacteriophages
3.9. Restriction Fragment Length Polymorphism (RFLP) of Bacteriophage DNA
3.10. Random Amplified Polymorphic DNA (RAPD)-PCR Analysis
3.11. Analysis of Bacteriophage Structural Proteins
3.12. Phylogenetic Analysis
4. Limitation of This Current Study
5. Conclusions
Author Contributions
Funding
Institutional Review Board Statement
Informed Consent Statement
Data Availability Statement
Acknowledgments
Conflicts of Interest
References
- Mulani, M.S.; Kamble, E.; Kumkar, S.N.; Tawre, M.S.; Pardesi, K.R. Emerging Strategies to Combat ESKAPE Pathogens in the Era of Antimicrobial Resistance: A Review. Front. Microbiol. 2019, 10, 539. [Google Scholar] [CrossRef] [PubMed]
- Abadi, A.T.B.; Rizvanov, A.A.; Haertlé, T.; Blatt, N.L. World Health Organization Report: Current Crisis of Antibiotic Resistance. Bionanoscience 2019, 9, 778–788. [Google Scholar] [CrossRef]
- Dadgostar, P. Antimicrobial Resistance: Implications and Costs. Infect. Drug Resist. 2019, 12, 3903–3910. [Google Scholar] [CrossRef] [PubMed]
- De Kraker, M.E.A.; Stewardson, A.J.; Harbarth, S. Will 10 Million People Die a Year due to Antimicrobial Resistance by 2050? PLoS Med. 2016, 13, e1002184. [Google Scholar] [CrossRef] [PubMed]
- Fair, R.J.; Tor, Y. Antibiotics and Bacterial Resistance in the 21st Century. Perspect. Med. Chem. 2014, 6, S14459. [Google Scholar] [CrossRef]
- Paczosa, M.K.; Mecsas, J. Klebsiella pneumoniae: Going on the Offense with a Strong Defense. Microbiol. Mol. Biol. Rev. 2016, 80, 629–661. [Google Scholar] [CrossRef]
- Da Costa, R.L.; Lamas, C.D.C.; Simvoulidis, L.F.N.; Espanha, C.A.; Moreira, L.P.M.; Bonancim, R.A.B.; Weber, J.V.L.A.; Ramos, M.R.F.; Silva, E.C.D.F.; de Oliveira, L.P. Secondary infections in a cohort of patients with COVID-19 admitted to an intensive care unit: Impact of gram-negative bacterial resistance. Rev. Inst. Med. Trop. São Paulo 2022, 64, e6. [Google Scholar] [CrossRef]
- Xu, J.; Zhao, Z.; Ge, Y.; He, F. Rapid Emergence of a Pandrug-Resistant Klebsiella pneumoniae ST11 Isolate in an Inpatient in a Teaching Hospital in China after Treatment with Multiple Broad-Spectrum Antibiotics. Infect. Drug Resist. 2020, 13, 799–804. [Google Scholar] [CrossRef]
- Asri, N.A.M.; Ahmad, S.; Mohamud, R.; Hanafi, N.M.; Zaidi, N.F.M.; Irekeola, A.A.; Shueb, R.H.; Yee, L.C.; Noor, N.M.; Mustafa, F.H.; et al. Global Prevalence of Nosocomial Multidrug-Resistant Klebsiella pneumoniae: A Systematic Review and Meta-Analysis. Antibiotics 2021, 10, 1508. [Google Scholar] [CrossRef]
- Mollers, M.; Lutgens, S.P.; Schoffelen, A.F.; Schneeberger, P.M.; Suijkerbuijk, A.W. Cost of Nosocomial Outbreak Caused by NDM-1–Containing Klebsiella pneumoniae in the Netherlands, October 2015–January 2016. Emerg. Infect. Dis. 2017, 23, 1574–1576. [Google Scholar] [CrossRef]
- Li, X.; He, Y.; Wang, Z.; Wei, J.; Hu, T.; Si, J.; Tao, G.; Zhang, L.; Xie, L.; Abdalla, A.E.; et al. A combination therapy of Phages and Antibiotics: Two is better than one. Int. J. Biol. Sci. 2021, 17, 3573–3582. [Google Scholar] [CrossRef] [PubMed]
- Voelker, R. FDA Approves Bacteriophage Trial. JAMA 2019, 321, 638. [Google Scholar] [CrossRef] [PubMed]
- Mousavi, S.M.; Babakhani, S.; Moradi, L.; Karami, S.; Shahbandeh, M.; Mirshekar, M.; Mohebi, S.; Moghadam, M.T. Bacteriophage as a Novel Therapeutic Weapon for Killing Colistin-Resistant Multi-Drug-Resistant and Extensively Drug-Resistant Gram-Negative Bacteria. Curr. Microbiol. 2021, 78, 4023–4036. [Google Scholar] [CrossRef] [PubMed]
- Di Lallo, G.; Evangelisti, M.; Mancuso, F.; Ferrante, P.; Marcelletti, S.; Tinari, A.; Superti, F.; Migliore, L.; D’Addabbo, P.; Frezza, D.; et al. Isolation and partial characterization of bacteriophages infecting Pseudomonas syringae pv. actinidiae, causal agent of kiwifruit bacterial canker. J. Basic Microbiol. 2014, 54, 1210–1221. [Google Scholar] [CrossRef] [PubMed]
- Yang, M.; Chen, H.; Huang, Q.; Xie, Z.; Liu, Z.; Zhang, J.; Ding, Y.; Chen, M.; Xue, L.; Wu, Q.; et al. Characterization of the Novel Phage vB_VpaP_FE11 and Its Potential Role in Controlling Vibrio parahaemolyticus Biofilms. Viruses 2022, 14, 264. [Google Scholar] [CrossRef] [PubMed]
- Baqer, A.A.; Wai, Y.C.; Adnan, S.N.A.; Nor, N.S.M. Morphology Characterization of Ten Lytic Bacterio-phages from Different Family Targeting Klebsiella pneumoniae. Malays. J. Microsc. 2021, 17, 1–20. [Google Scholar]
- Kropinski, A.M. Practical Advice on the One-Step Growth Curve. Methods Mol. Biol. 2018, 1681, 41–47. [Google Scholar] [CrossRef] [PubMed]
- Ye, Y.; Chen, H.; Huang, Q.; Huang, S.; He, J.; Zhang, J.; Wu, Q.; Li, X.; Hu, W.; Yang, M. Characterization and Genomic Analysis of Novel Vibrio parahaemolyticus Phage vB_VpaP_DE10. Viruses 2022, 14, 1609. [Google Scholar] [CrossRef]
- Jończyk, E.; Kłak, M.; Międzybrodzki, R.; Górski, A. The influence of external factors on bacteriophages—Review. Folia Microbiol. 2011, 56, 191–200. [Google Scholar] [CrossRef]
- Droubogiannis, S.; Pavlidi, L.; Tsertou, M.I.; Kokkari, C.; Skliros, D.; Flemetakis, E.; Katharios, P. Vibrio Phage Artemius, a Novel Phage Infecting Vibrio alginolyticus. Pathogens 2022, 11, 848. [Google Scholar] [CrossRef]
- Sambrook, J.; Russell, D.W.; Russell, D. Molecular Cloning: A Laboratory Manual (3-Volume Set); Cold Spring Harbor Laboratory Press: New York, NY, USA, 2001. [Google Scholar]
- Ramos, P.I.P.; Picão, R.C.; Vespero, E.C.; Pelisson, M.; Zuleta, L.F.G.; Almeida, L.G.P.; Gerber, A.L.; Vasconcelos, A.T.R.; Gales, A.C.; Nicolás, M.F. Pyrosequencing-based analysis reveals a novel capsular gene cluster in a KPC-producing Klebsiella pneumoniae clinical isolate identified in Brazil. BMC Microbiol. 2012, 12, 173. [Google Scholar] [CrossRef] [PubMed]
- Mateus, L.; Costa, L.; Silva, Y.; Pereira, C.; Cunha, A.; Almeida, A. Efficiency of phage cocktails in the inactivation of Vibrio in aquaculture. Aquaculture 2014, 424-425, 167–173. [Google Scholar] [CrossRef]
- Le, T.S.; Nguyen, T.H.; Vo, H.P.; Doan, V.C.; Nguyen, H.L.; Tran, M.T.; Tran, T.T.; Southgate, P.C.; Kurtböke, D.I. Protective Effects of Bacteriophages against Aeromonas hydrophila Causing Motile Aeromonas Septicemia (MAS) in Striped Catfish. Antibiotics 2018, 7, 16. [Google Scholar] [CrossRef] [PubMed]
- Comeau, A.M.; Short, S.; Suttle, C.A. The use of degenerate-primed random amplification of polymorphic DNA (DP-RAPD) for strain-typing and inferring the genetic similarity among closely related viruses. J. Virol. Methods 2004, 118, 95–100. [Google Scholar] [CrossRef] [PubMed]
- Gutiérrez, D.; Platero, A.M.M.; Rodriguez, A.; Bueno, M.M.; García, P.; Martínez, B. Typing of bacteriophages by randomly amplified polymorphic DNA (RAPD)-PCR to assess genetic diversity. FEMS Microbiol. Lett. 2011, 322, 90–97. [Google Scholar] [CrossRef] [PubMed]
- Pinarkara, E.; Kayis, S.A.; Hakki, E.E.; Sag, A. RAPD analysis of seized marijuana (Cannabis sativa L.) in Turkey. Electron. J. Biotechnol. 2009, 12, 5–6. [Google Scholar] [CrossRef]
- McNair, K.; Zhou, C.; Dinsdale, E.; Souza, B.; Edwards, R. PHANOTATE: A novel approach to gene identification in phage genomes. Bioinformatics 2019, 35, 4537–4542. [Google Scholar] [CrossRef]
- Götz, S.; Garcia-Gomez, J.M.; Terol, J.; Williams, T.D.; Nagaraj, S.H.; Nueda, M.J.; Robles, M.; Talón, M.; Dopazo, J.; Conesa, A. High-throughput functional annotation and data mining with the Blast2GO suite. Nucleic Acids Res. 2008, 36, 3420–3435. [Google Scholar] [CrossRef]
- Kumar, S.; Stecher, G.; Tamura, K. MEGA7: Molecular Evolutionary Genetics Analysis Version 7.0 for Bigger Datasets. Mol. Biol. Evol. 2016, 33, 1870–1874. [Google Scholar] [CrossRef]
- Necel, A.; Bloch, S.; Nejman-Faleńczyk, B.; Grabski, M.; Topka, G.; Dydecka, A.; Kosznik-Kwaśnicka, K.; Grabowski, L.; Jurczak-Kurek, A.; Wołkowicz, T.; et al. Characterization of a bacteriophage, vB_Eco4M-7, that effectively infects many Escherichia coli O157 strains. Sci. Rep. 2020, 10, 3743. [Google Scholar] [CrossRef]
- Tabassum, R.; Shafique, M.; Khawaja, K.A.; Alvi, I.A.; Rehman, Y.; Sheik, C.; Abbas, Z.; Rehman, S.U. Complete genome analysis of a Siphoviridae phage TSK1 showing biofilm removal potential against Klebsiella pneumoniae. Sci. Rep. 2018, 8, 1–11. [Google Scholar] [CrossRef] [PubMed]
- Cornelissen, A.; Ceyssens, P.-J.; Krylov, V.N.; Noben, J.-P.; Volckaert, G.; Lavigne, R. Identification of EPS-degrading activity within the tail spikes of the novel Pseudomonas putida phage AF. Virology 2012, 434, 251–256. [Google Scholar] [CrossRef] [PubMed]
- Abedon, S.T. Bacteriophage exploitation of bacterial biofilms: Phage preference for less mature targets? FEMS Microbiol. Lett. 2016, 363, fnv246. [Google Scholar] [CrossRef] [PubMed]
- Maciejewska, B.; Roszniowski, B.; Espaillat, A.; Kęsik-Szeloch, A.; Majkowska-Skrobek, G.; Kropinski, A.M.; Briers, Y.; Cava, F.; Lavigne, R.; Drulis-Kawa, Z. Klebsiella phages representing a novel clade of viruses with an unknown DNA modification and biotechnologically interesting enzymes. Appl. Microbiol. Biotechnol. 2016, 101, 673–684. [Google Scholar] [CrossRef]
- Cao, Y.; Li, S.; Han, S.; Wang, D.; Zhao, J.; Xu, L.; Liu, H.; Lu, T. Characterization and application of a novel Aeromonas bacteriophage as treatment for pathogenic Aeromonas hydrophila infection in rainbow trout. Aquaculture 2020, 523, 735193. [Google Scholar] [CrossRef]
- Sun, W.-J.; Liu, C.-F.; Yu, L.; Cui, F.-J.; Zhou, Q.; Yu, S.-L.; Sun, L. A novel bacteriophage KSL-1 of 2-Keto-gluconic acid producer Pseudomonas fluorescens K1005: Isolation, characterization and its remedial action. BMC Microbiol. 2012, 12, 127. [Google Scholar] [CrossRef]
- Lu, Z.; Breidt, F.; Fleming, H.; Altermann, E.; Klaenhammer, T. Isolation and characterization of a Lactobacillus plantarum bacteriophage, ΦJL-1, from a cucumber fermentation. Int. J. Food Microbiol. 2003, 84, 225–235. [Google Scholar] [CrossRef]
- Karumidze, N.; Kusradze, I.; Rigvava, S.; Goderdzishvili, M.; Rajakumar, K.; Alavidze, Z. Isolation and Characterisation of Lytic Bacteriophages of Klebsiella pneumoniae and Klebsiella oxytoca. Curr. Microbiol. 2012, 66, 251–258. [Google Scholar] [CrossRef]
- Drulis-Kawa, Z.; Mackiewicz, P.; Kęsik-Szeloch, A.; Maciaszczyk-Dziubinska, E.; Weber-Dąbrowska, B.; Dorotkiewicz-Jach, A.; Augustyniak, D.; Majkowska-Skrobek, G.; Bocer, T.; Empel, J.; et al. Isolation and characterisation of KP34—A novel φKMV-like bacteriophage for Klebsiella pneumoniae. Appl. Microbiol. Biotechnol. 2011, 90, 1333–1345. [Google Scholar] [CrossRef]
- Ma, Y.; Li, E.; Qi, Z.; Li, H.; Wei, X.; Lin, W.; Zhao, R.; Jiang, A.; Yang, H.; Yin, Z.; et al. Isolation and molecular characterisation of Achromobacter phage phiAxp-3, an N4-like bacteriophage. Sci. Rep. 2016, 6, 24776. [Google Scholar] [CrossRef]
- Choi, C.; Kuatsjah, E.; Wu, E.; Yuan, S. The Effect of Cell Size on the Burst Size of T4 Bacteriophage Infections of Escherichia Coli B23. J. Exp. Microbiol. Immunol. 2010, 14, 85–91. [Google Scholar]
- Droubogiannis, S.; Katharios, P. Genomic and Biological Profile of a Novel Bacteriophage, Vibrio phage Virtus, Which Improves Survival of Sparus aurata Larvae Challenged with Vibrio harveyi. Pathogens 2022, 11, 630. [Google Scholar] [CrossRef] [PubMed]
- Manohar, P.; Tamhankar, A.J.; Lundborg, C.S.; Nachimuthu, R. Therapeutic Characterization and Efficacy of Bacteriophage Cocktails Infecting Escherichia coli, Klebsiella pneumoniae, and Enterobacter Species. Front. Microbiol. 2019, 10, 574. [Google Scholar] [CrossRef] [PubMed]
- Sillankorva, S.; Neubauer, P.; Azeredo, J. Isolation and characterization of a T7-like lytic phage for Pseudomonas fluorescens. BMC Biotechnol. 2008, 8, 80. [Google Scholar] [CrossRef] [PubMed]
- Gallet, R.; Shao, Y.; Wang, I.-N. High adsorption rate is detrimental to bacteriophage fitness in a biofilm-like environment. BMC Evol. Biol. 2009, 9, 241. [Google Scholar] [CrossRef]
- Verma, V.; Harjai, K.; Chhibber, S. Characterization of a T7-Like Lytic Bacteriophage of Klebsiella pneumoniae B5055: A Potential Therapeutic Agent. Curr. Microbiol. 2009, 59, 274–281. [Google Scholar] [CrossRef]
- Ackermann, H.; Tremblay, D.; Moineau, S. Long-Term Bacteriophage Preservation. WFCC Newsletter 2004, 38, 35–40. [Google Scholar]
- Chen, Y.; Guo, G.; Sun, E.; Song, J.; Yang, L.; Zhu, L.; Liang, W.; Hua, L.; Peng, Z.; Tang, X.; et al. Isolation of a T7-Like Lytic Pasteurella Bacteriophage vB_PmuP_PHB01 and Its Potential Use in Therapy against Pasteurella multocida Infections. Viruses 2019, 11, 86. [Google Scholar] [CrossRef]
- Lim, J.-A. Biocontrol of Pectobacterium carotovorum subsp. carotovorum Using Bacteriophage PP1. J. Microbiol. Biotechnol. 2013, 23, 1147–1153. [Google Scholar] [CrossRef]
- Ateba, C.N.; Akindolire, M.A. Isolation and Characterisation of Bacteriophages with Lytic Activity against Virulent Escherichia Coli O157: H7: Potential Bio-Control Agents. Preprints 2019, 2019010132. [Google Scholar]
- Bai, J.; Zhang, F.; Liang, S.; Chen, Q.; Wang, W.; Wang, Y.; Martín-Rodríguez, A.J.; Sjöling; Hu, R.; Zhou, Y. Isolation and Characterization of vB_kpnM_17-11, a Novel Phage Efficient against Carbapenem-Resistant Klebsiella pneumoniae. Front. Cell. Infect. Microbiol. 2022, 12, 897531. [Google Scholar] [CrossRef] [PubMed]
- Lu, Y.; Shi, H.; Zhang, Z.; Han, F.; Li, J.; Sun, Y. Isolation and characterization of a lytic bacteriophage φKp-lyy15 of Klebsiella pneumoniae. Virol. Sin. 2015, 30, 66–68. [Google Scholar] [CrossRef] [PubMed]
- Smolarska, A.; Rabalski, L.; Narajczyk, M.; Czajkowski, R. Isolation and phenotypic and morphological characterization of the first Podoviridae lytic bacteriophages ϕA38 and ϕA41 infecting Pectobacterium parmentieri (former Pectobacterium wasabiae). Eur. J. Plant Pathol. 2017, 150, 413–425. [Google Scholar] [CrossRef]
- Fan, N.; Qi, R.; Yang, M. Isolation and characterization of a virulent bacteriophage infecting Acinetobacter johnsonii from activated sludge. Res. Microbiol. 2017, 168, 472–481. [Google Scholar] [CrossRef] [PubMed]
- Aniejurengho, O.U.V. Dendron-Based Synthetic Bacteriophages for the Treatment of Proteus Mirabilis Infections; University of Brighton: Brighton, UK, 2016. [Google Scholar]
- Fortier, L.-C.; Moineau, S. Phage Production and Maintenance of Stocks, Including Expected Stock Lifetimes. Methods Mol. Biol. 2009, 501, 203–219. [Google Scholar] [CrossRef]
- Carlson, K. Working with Bacteriophages: Common Techniques and Methodological Approaches; CRC Press: Boca Raton, FL, USA, 2005. [Google Scholar]
- Alvi, I.A.; Asif, M.; Tabassum, R.; Abbas, Z.; Rehman, S.U. Storage of Bacteriophages at 4 °C Leads to no Loss in Their Titer after One Year. Pak. J. Zool. 2018, 50, 1999–2398. [Google Scholar] [CrossRef]
- González-Menéndez, E.; Fernández, L.; Gutiérrez, D.; Rodríguez, A.; Martínez, B.; García, P. Comparative analysis of different preservation techniques for the storage of Staphylococcus phages aimed for the industrial development of phage-based antimicrobial products. PLoS ONE 2018, 13, e0205728. [Google Scholar] [CrossRef]
- Serwer, P.; Hayes, S.J.; Lieman, K. Aggregates of bacteriophage 0305φ8-36 seed future growth. Virol. J. 2007, 4, 131. [Google Scholar] [CrossRef]
- Clark, W.A. Comparison of Several Methods for Preserving Bacteriophages. Appl. Microbiol. 1962, 10, 466–471. [Google Scholar] [CrossRef]
- Akhtar, M.; Viazis, S.; Diez-Gonzalez, F. Isolation, identification and characterization of lytic, wide host range bacteriophages from waste effluents against Salmonella enterica serovars. Food Control. 2014, 38, 67–74. [Google Scholar] [CrossRef]
- Akhwale, J.K.; Rohde, M.; Rohde, C.; Bunk, B.; Spröer, C.; Boga, H.I.; Klenk, H.-P.; Wittmann, J. Isolation, characterization and analysis of bacteriophages from the haloalkaline lake Elmenteita, Kenya. PLoS ONE 2019, 14, e0215734. [Google Scholar] [CrossRef] [PubMed]
- Foor, F.; Roberts, G.P.; Morin, N.; Snyder, L.; Hwang, M.; Gibbons, P.H.; Paradiso, M.J.; Stotish, R.L.; Ruby, C.L.; Wolanski, B.; et al. Isolation and characterization of the Streptomyces cattleya temperate phage TG1. Gene 1985, 39, 11–16. [Google Scholar] [CrossRef] [PubMed]
- Maszewska, A.; Wojcik, E.; Ciurzyńska, A.; Wojtasik, A.; Piątkowska, I.; Dastych, J.; Rozalski, A. Differentiation of polyvalent bacteriophages specific to uropathogenic Proteus mirabilis strains based on the host range pattern and RFLP. Acta Biochim. Pol. 2016, 63, 303–310. [Google Scholar] [CrossRef] [PubMed]
- Sharp, P. Molecular evolution of bacteriophages: Evidence of selection against the recognition sites of host restriction enzymes. Mol. Biol. Evol. 1986, 3, 75–83. [Google Scholar] [CrossRef]
- Krüger, D.H.; A Bickle, T. Bacteriophage survival: Multiple mechanisms for avoiding the deoxyribonucleic acid restriction systems of their hosts. Microbiol. Rev. 1983, 47, 345–360. [Google Scholar] [CrossRef]
- Shen, M.; Le, S.; Jin, X.; Li, G.; Tan, Y.; Li, M.; Zhao, X.; Shen, W.; Yang, Y.; Wang, J.; et al. Characterization and Comparative Genomic Analyses of Pseudomonas aeruginosa Phage PaoP5: New Members Assigned to PAK_P1-like Viruses. Sci. Rep. 2016, 6, 34067. [Google Scholar] [CrossRef]
- Holmfeldt, K.; Middelboe, M.; Nybroe, O.; Riemann, L. Large Variabilities in Host Strain Susceptibility and Phage Host Range Govern Interactions between Lytic Marine Phages and Their Flavobacterium Hosts. Appl. Environ. Microbiol. 2007, 73, 6730–6739. [Google Scholar] [CrossRef]
- Wang, C.; Li, P.; Niu, W.; Yuan, X.; Liu, H.; Huang, Y.; An, X.; Fan, H.; Zhangxiang, L.; Mi, L.; et al. Protective and therapeutic application of the depolymerase derived from a novel KN1 genotype of Klebsiella pneumoniae bacteriophage in mice. Res. Microbiol. 2019, 170, 156–164. [Google Scholar] [CrossRef]
- Chopin, A.; Bolotin, A.; Sorokine, A.; Ehrlich, S.D.; Chopin, M.-C. Analysis of six prophages in Lactococcus lactis IL1403: Different genetic structure of temperate and virulent phage populations. Nucleic Acids Res. 2001, 29, 644–651. [Google Scholar] [CrossRef]
- Addablah, A.A.; Kakou-Ngazoa, S.; Akpa, E.E.; Adioumani, E.; Ndombi, F.M.; Aoussi, S.; Dosso, M. RAPD-based evaluation revealed genetically diverse populations of Pseudomonas aeruginosa and Staphylococcus aureus lytic bacteriophages isolated in urban sewage and Ebrie Lagoon, Côte d’Ivoire. Afr. J. Microbiol. Res. 2021, 15, 522–528. [Google Scholar]
- Gutiérrez, D.; Martínez, B.; Rodríguez, A.; García, P. Isolation and Characterization of Bacteriophages Infecting Staphylococcus epidermidis. Curr. Microbiol. 2010, 61, 601–608. [Google Scholar] [CrossRef] [PubMed]
- Kumari, S. Evidence to Support the Therapeutic Potential of Bacteriophage Kpn5 in Burn Wound Infection Caused by Klebsiella pneumoniae in BALB/c Mice. J. Microbiol. Biotechnol. 2010, 20, 935–941. [Google Scholar] [CrossRef] [PubMed]
- Gerstmans, H.; Rodríguez-Rubio, L.; Lavigne, R.; Briers, Y. From endolysins to Artilysin®s: Novel enzyme-based approaches to kill drug-resistant bacteria. Biochem. Soc. Trans. 2016, 44, 123–128. [Google Scholar] [CrossRef] [PubMed]
- Nasko, D.J.; Chopyk, J.; Sakowski, E.G.; Ferrell, B.D.; Polson, S.W.; Wommack, K.E. Family A DNA Polymerase Phylogeny Uncovers Diversity and Replication Gene Organization in the Virioplankton. Front. Microbiol. 2018, 9, 3053. [Google Scholar] [CrossRef] [PubMed]
- Le, S.; He, X.; Tan, Y.; Huang, G.; Zhang, L.; Lux, R.; Shi, W.; Hu, F. Mapping the Tail Fiber as the Receptor Binding Protein Responsible for Differential Host Specificity of Pseudomonas aeruginosa Bacteriophages PaP1 and JG004. PLoS ONE 2013, 8, e68562. [Google Scholar] [CrossRef]
- Tan, D.; Zhang, Y.; Cheng, M.; Le, S.; Gu, J.; Bao, J.; Qin, J.; Guo, X.; Zhu, T. Characterization of Klebsiella pneumoniae ST11 Isolates and Their Interactions with Lytic Phages. Viruses 2019, 11, 1080. [Google Scholar] [CrossRef]
- Cornelissen, A.; Ceyssens, P.-J.; T’Syen, J.; Van Praet, H.; Noben, J.-P.; Shaburova, O.V.; Krylov, V.N.; Volckaert, G.; Lavigne, R. The T7-Related Pseudomonas putida Phage φ15 Displays Virion-Associated Biofilm Degradation Properties. PLoS ONE 2011, 6, e18597. [Google Scholar] [CrossRef]
- Yan, J.; Mao, J.; Xie, J. Bacteriophage Polysaccharide Depolymerases and Biomedical Applications. Biodrugs 2013, 28, 265–274. [Google Scholar] [CrossRef]
- Pires, D.; Sillankorva, S.; Faustino, A.; Azeredo, J. Use of newly isolated phages for control of Pseudomonas aeruginosa PAO1 and ATCC 10145 biofilms. Res. Microbiol. 2011, 162, 798–806. [Google Scholar] [CrossRef]

| Primer | Sequence | Reference |
|---|---|---|
| R10D | 5-GTCASSWSSW-3 | [25] |
| RAPD5 | 5-AACGCGCAAC-3 | [26] |
| RAPD2 | 5-CCGCAGCCAA-3 | [26] |
| RAPD3 | 5-AACGGGCAGA-3 | [26] |
| RAPD 1 | 5-GTAGACCCGT-3 | [27] |
| Phage | K2a | K2b | K2w5 | K2w6 | Kp99 | K9w5 | K9w6 | K9coc |
|---|---|---|---|---|---|---|---|---|
| Clear zone (mm) | 1.5 | 1.5 | 4 | 6 | 1 | 0.5 | 1 | 1 |
| Halo after 72 h (mm) | 0.5 | 6.5 | 4 | 5 | 5 | 0.5 | 6 | 7 |
| K. pneumoniae Bacteriophage | K. pneumoniae Host | Latent Period | Burst Size | MOI | Genome Size (kb) |
|---|---|---|---|---|---|
| K2a | KP2 | 5 | 116 | 0.01 | 36 |
| K2b | KP2 | 20 | 41 | 0.01 | 62 |
| K2w5 | KP2 | 20 | 354 | 0.01 | 87 |
| K2w6 | KP2 | 25 | 106 | 0.1 | 62 |
| Kp99 | KP9 | 20 | 214 | 0.1 | 64 |
| K9w5 | KP9 | 30 | 66 | 0.001 | 64 |
| K9w6 | KP9 | 10 | 130 | 0.1 | 36 |
| K9coc | KP9 | 10 | 210 | 0.01 | 36 |
| Endonuclease | Restriction Site (5′ to 3′) |
|---|---|
| PstI | CTGCA/G |
| XhoI | C/TCGAG |
| XbaI | T/CTAGA |
| EcoRI | G/AATTC |
| SmaI | CCC/GGG |
| NedI | CA/TATG |
Disclaimer/Publisher’s Note: The statements, opinions and data contained in all publications are solely those of the individual author(s) and contributor(s) and not of MDPI and/or the editor(s). MDPI and/or the editor(s) disclaim responsibility for any injury to people or property resulting from any ideas, methods, instructions or products referred to in the content. |
© 2022 by the authors. Licensee MDPI, Basel, Switzerland. This article is an open access article distributed under the terms and conditions of the Creative Commons Attribution (CC BY) license (https://creativecommons.org/licenses/by/4.0/).
Share and Cite
Baqer, A.A.; Fang, K.; Mohd-Assaad, N.; Adnan, S.N.A.; Md Nor, N.S. In Vitro Activity, Stability and Molecular Characterization of Eight Potent Bacteriophages Infecting Carbapenem-Resistant Klebsiella pneumoniae. Viruses 2023, 15, 117. https://doi.org/10.3390/v15010117
Baqer AA, Fang K, Mohd-Assaad N, Adnan SNA, Md Nor NS. In Vitro Activity, Stability and Molecular Characterization of Eight Potent Bacteriophages Infecting Carbapenem-Resistant Klebsiella pneumoniae. Viruses. 2023; 15(1):117. https://doi.org/10.3390/v15010117
Chicago/Turabian StyleBaqer, Abeer Ameen, Kokxin Fang, Norfarhan Mohd-Assaad, Siti Noor Adnalizawati Adnan, and Norefrina Shafinaz Md Nor. 2023. "In Vitro Activity, Stability and Molecular Characterization of Eight Potent Bacteriophages Infecting Carbapenem-Resistant Klebsiella pneumoniae" Viruses 15, no. 1: 117. https://doi.org/10.3390/v15010117
APA StyleBaqer, A. A., Fang, K., Mohd-Assaad, N., Adnan, S. N. A., & Md Nor, N. S. (2023). In Vitro Activity, Stability and Molecular Characterization of Eight Potent Bacteriophages Infecting Carbapenem-Resistant Klebsiella pneumoniae. Viruses, 15(1), 117. https://doi.org/10.3390/v15010117







